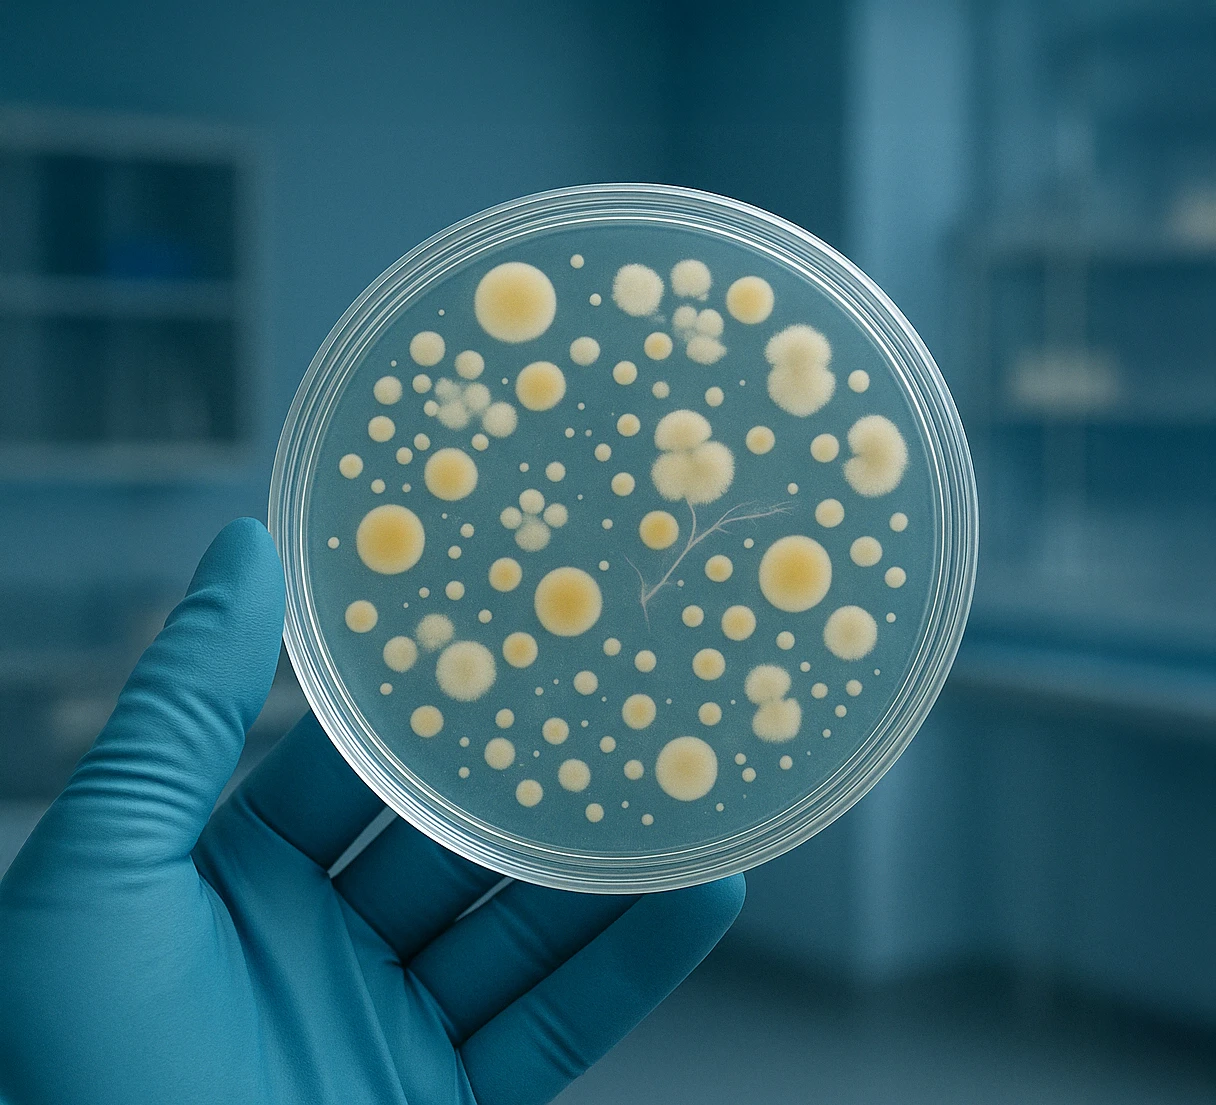
Chatgpt Image 16. Apr. 2025, 14 31 Neu

Klimaanlage und Pollenfilter: Warum jetzt der beste Zeitpunkt für einen Check ist
Frühjahrs-Check für Ihre Klimaanlage
Jetzt ist der perfekte Zeitpunkt: Die Tage werden länger, die Sonne scheint öfter, und die Temperaturen klettern langsam nach oben. Der Frühling kündigt sich an, es ist höchste Zeit, Ihre Klimaanlage und den Pollenfilter überprüfen zu lassen. Doch was passiert, wenn Sie Ihre Klimaanlage und den Pollenfilter nicht rechtzeitig überprüfen lassen? Es drohen unangenehme Überraschungen: schlechtere Kühlleistung, höhere Energiekosten, unangenehme Gerüche oder sogar allergische Beschwerden. Warum genau jetzt der richtige Moment für einen Check ist, erfahren Sie hier.
Vorteile einer gut gewarteten Klimaanlage
Eine optimal funktionierende Klimaanlage ist leise, zuverlässig und verbraucht weniger Energie. Das spart Geld und schont die Umwelt. Zusätzlich reduziert eine regelmäßige Wartung die Gefahr von unangenehmen Gerüchen im Auto. Eine ungepflegte Anlage bietet ideale Bedingungen für Bakterien, die dann unangenehme Gerüche verursachen können.
Was passiert bei einem professionellen Klimaanlagen- und Pollenfiltercheck?
- Prüfung Funktion der Klimaanlage: Ein Spezialist überprüft die Kühlleistung, führt eine Druckprüfung durch, um deren einwandfreie Funktion sicherzustellen
- Reinigung und Desinfektion: Die Klimaanlage wird professionell von Schmutz sowie Keimen und Bakterien befreit
- Kontrolle und Austausch des Kältemittels: Der Kältemittelstand wird überprüft und bei Bedarf nachgefüllt oder erneuert, um optimale Kühlleistung sicherzustellen
- Prüfung und Wechsel des Pollenfilters: Der Filter wird auf Verschmutzungen und Verstopfungen untersucht und bei Bedarf erneuert
Eine regelmäßig gewartete Klimaanlage mit einem sauberen und funktionstüchtigen Pollenfilter sorgt für angenehmes Klima und gesunde, frische Luft im Fahrzeuginneren. Durch professionelle Wartungen vermeiden Sie unangenehme Situationen. Empfehlenswert ist daher eine regelmäßige Überprüfung, mindestens einmal jährlich oder bei auftretenden Anzeichen.
💡 Good to know
-
Wie oft sollte die Klimaanlage im Auto gewartet werden?
Empfohlen wird eine Wartung einmal im Jahr, idealerweise im Frühling.
-
Warum riecht die Klimaanlage nach dem Einschalten unangenehm?
Oft ist das ein Zeichen für Bakterien, Pilze oder Schimmel im Verdampfer oder Filter. Diese Mikroorganismen setzen sich bei hoher Luftfeuchtigkeit und mangelnder Wartung fest – ein Fall für eine professionelle Reinigung.
-
Kann ich durch die Klimaanlage im Auto krank werden?
Nicht direkt. Eine saubere Anlage schadet nicht, im Gegenteil: Sie kann Erkältungen sogar vorbeugen, weil sie die Luft entfeuchtet. Aber eine nicht gewartete Anlage kann Bakterien oder Schimmel verbreiten, was zu Reizungen oder Kopfschmerzen führen kann
Praktisches Zubehör für zusätzlichen Schutz
Bereit für frische Luft und ein angenehmes Fahrgefühl? Mit einer gewarteten Klimaanlage und einem sauberen Pollenfilter starten Sie bestens vorbereitet – besonders während der Allergiesaison. Rüsten Sie Ihr Fahrzeug zusätzlich mit praktischem Zubehör auf, das Sie jederzeit unterstützt. Denken Sie daran, Ihre Klimaanlage regelmäßig zu überprüfen - für maximalen Fahrkomfort.